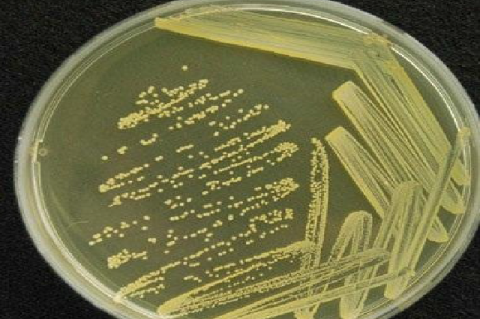
Streak plate of the Isolate

Asian Journal of Biological and Life sciences, Vol 1, Issue 3, Sep-Dec, 2012
Recent Articles
Review Article
Improvement in Productivity of Wheat with Crop Residue and Nitrogen -A Review
Avtar Singh,Meenakshi Kaushal,Harmeet Singh
Asian J. Biol. Life Sci.,1(3):139-146 Read More
Short Communication
Seasonal Variability of Some Enteromorpha Species in Kanyakumari Region, the Southern Coast of Tamil Nadu
John Peter Paul J,Patric Raja D
Asian J. Biol. Life Sci.,1(3):147-149 Read More
Short Communication
Evaluation of Selective Nutritional and Antinutritional Components in Underground Storage Organs
S.Chidambaram Pillai,N .Suresh,M .Padmasree
Asian J. Biol. Life Sci.,1(3):150-153 Read More
Original Research
Study on the Impact of Site Specific Nutrient Management Technologies in Rice Under Irrigated Domains of Kurnool District of Andhra Pradesh
K .V.Ramanaiah,G .Dhanalakshmi,G .RajenderReddy,A.Krishna Murthy,M .Sudhakar
Asian J. Biol. Life Sci.,1(3):154-158 Read More
Research Article
Effect of Malathion on Physio-Biological Aspects of Notopterus notopterus (Pallas)
Manoj kumarAhirwar,Q . J. . Shammi,Salman Raouf Chalko,Gh. Nabi Lone
Asian J. Biol. Life Sci.,1(3):159-163 Read More
Original Research
Bacteria Associated with Septicemia in Children and their Antimicrobial Sensitivity Pattern, Kano, Nigeria
Kashibu E,Ihesiulor G.U,Adeleke S. I,Tasabeeh M.H
Asian J. Biol. Life Sci.,1(3):174-177 Read More
Original Research
Distribution of Complement Component 4 (C4) Isotype -A Null Phenotype (C4AQ0) in Normal Healthy North Indian Subjects
RiyazAlam Mansoori,Monika Gandhi
Asian J. Biol. Life Sci.,1(3):178-180 Read More
Original Research
Prevalence of Thinness Among Rural Pre-school Children of East Midnapur, West Bengal, India.
Gopal Chandra Mandal,Atanu Acharya,Kaushik Bose
Asian J. Biol. Life Sci.,1(3):181-185 Read More
Original Research
Detection of Bla CTX-M gene on Resistant Salmonella enterica serovar from a Hospital in Southeast Nigeria
Adeleke O.E,Onyenwe N.E,Mbata T.I
Asian J. Biol. Life Sci.,1(3):186-190 Read More
Research Article
Optimization of PCR Conditions to Amplify Mitochondrial COI Gene fragments of Wildlife Species in Kenya
Edinah Song'oro,Ann Muigai,Charles Kimwele,Erastus Gatebe,Mercy Mwaniki
Asian J. Biol. Life Sci.,1(3):191-196 Read More
Original Research
Effect of Radiotherapy and Chemotherapy on Serum Glycoproteins of Gynecological Cancers
Subramanyam Dasari,Raju Naidu DS,Rajendra Wudyagiri,Lokanatha Valluru
Asian J. Biol. Life Sci.,1(3):197-203 Read More
Research Article
Isolation, Screening and Identification of Organophosphate Pesticide Degrading Bacterium, Kocuria sp
N .Nagavardhanam,Z .Vishnuvardhan
Asian J. Biol. Life Sci.,1(3):204-207 Read More
Research Article
Reactivity of Digestive Mucins in freshwater Snail Bellamya bengalensis (l) Against Copper sulphate Induction
N AKamble,S B. Kamble
Asian J. Biol. Life Sci.,1(3):208-212 Read More
Research Article
Nitrogen fixation by the Native Azospirillum spp. Ssolated from Rhizosphere and Non-Rhizosphere of foxtail Millet
Mokula Md. Raffi,P.B.B.N. Charyulu1
Asian J. Biol. Life Sci.,1(3):213-218 Read More
Research Article
Antibacterial Activity of Seaweed (Gracilaria species) Extracts Against Infectious Pathogens
Prasad M. P,Shekhar Sushant,Rindhe Ganesh
Asian J. Biol. Life Sci.,1(3):219-222 Read More
Original Research
Back Extensor Endurance: A Comparison Between Normal Healthy Indian Adults
Rashmi Bhaval,Keerthi Rao,Chandra Iyer,S.M. Khatri
Asian J. Biol. Life Sci.,1(3):223-225 Read More
Research Article
Antiulcer Activity of Dodonaea viscosa Leaf Extract in Aspirin Induced Albino rats
K. Sathya,G. Prasanna
Asian J. Biol. Life Sci.,1(3):233-237 Read More
Research Article
Acute Toxicity of Cadmium and Lead to Adult Toad Bufo maculatus
Alex Ajeh Enuneku,Lawrence Ikechukwu Ezemonye
Asian J. Biol. Life Sci.,1(3):238-241 Read More
Research Article
Nutritional Composition, Phytochemical screening and Antimicrobial Properties of the Leaf of Ficus exasperata (Vahl)
O.B Ajayi,J.O Oluyege,O.M. Olalemi,T.M Ilesanmi
Asian J. Biol. Life Sci.,1(3):242-246 Read More
Research Article
Investigation of the Anxiolytic and Antidepressant Activity of Athanolic Extract of Whole Plant of Ashwagandha (Withania somnifera), a Popular Medicinal Plant of Indian Subcontinent
Ninadh Malrina D'Costa,Mehdi Bin Samad,Ashraf-ul Kabir,
Asian J. Biol. Life Sci.,1(3):247-251 Read More
Research Article
Antibacterial Activity Monascus purpureus (Red pigment) Isolated from Rice Malt
Ajay kumar,Usha verma,Heena sharma
Asian J. Biol. Life Sci.,1(3):252-255 Read More
Original Research
Documenting Angiosperm Diversity and Assigning Economic and Conservation Value of Kaan Forests: Traditionally Managed Climax Sacred Landscapes in Sagar Taluk of Central Western Ghats, India
Shrikant Gunaga,Rajeshwari N,Vasudeva R
Asian J. Biol. Life Sci.,1(3):164-173 Read More
Research Article